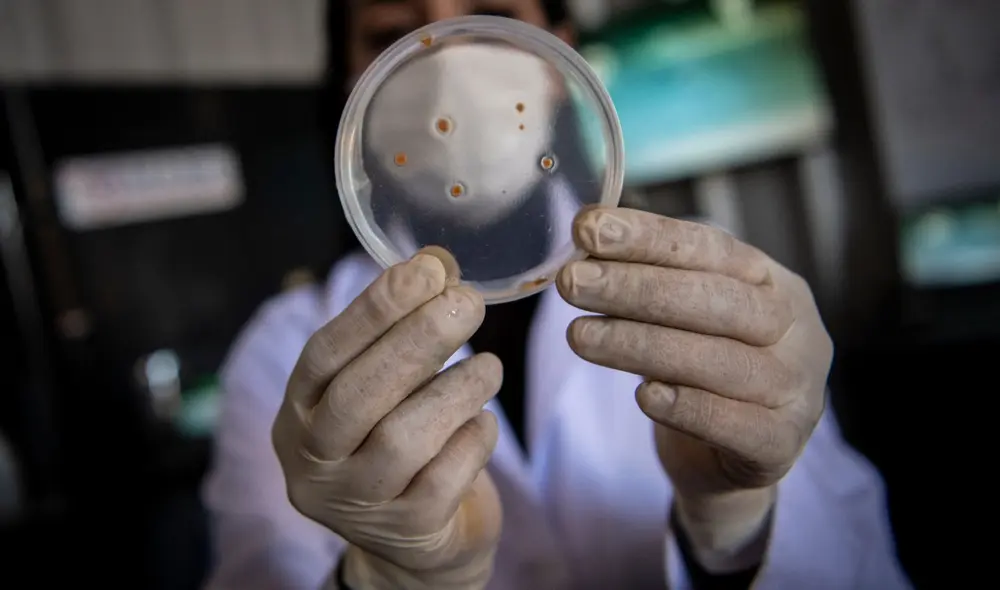
En el Perú están apareciendo bacterias resistentes a todo tipo de antibióticos. Foto: agencias. En el Perú están apareciendo bacterias resistentes a todo tipo de antibióticos. Foto: agencias.

Resistencia a los antibióticos: la pandemia silenciosa que crece en el Perú
Una reciente investigación ha detectado que el Perú es uno de los países con mayor resistencia a los antibióticos en el mundo. Hay fármacos que están resultando cada vez más inútiles para curar diversas infecciones. Los expertos piden mayor regulación en la industria de alimentos y detener la venta sin receta en farmacias.
El médico infectólogo Christian Resurrección recuerda claramente cuando, hace 11 años, hacía la especialidad y él y sus colegas tenían que vérselas con neumonías intrahospitalarias.
–Las manejábamos con quinolonas y cefalosporinas –dice, recordando días en los que todo parecía más sencillo. –Ahora es imposible tratarlas de esa forma. Ahora las pseudomonas se han vuelto altamente resistentes a estos antibióticos.
El doctor Resurrección recuerda un poco más. Hasta hace algunos años, dice, los pacientes que llegaban con infecciones urinarias a su hospital, el Hospital Dos de Mayo, solían recibir antibióticos simples, los llamados de primera línea. Un ciprofloxaxino. Una amoxicilina con ácido clavulánico. O una cefalosporina.
Pero ya no, dice. Las bacterias que causan la infección urinaria, la más frecuente de ellas la Escherichia coli, se han vuelto resistentes a esos medicamentos. Ahora los médicos tienen que recurrir a fármacos más complejos. Más caros.
Y, como explica Resurrección, si esta tendencia continúa, dentro de algunos años estos medicamentos también se tornarán ineficaces. Solo quedarán los llamados de último recurso. Y es posible que lleguemos a un punto en el que ni siquiera estos funcionen.
–Vamos a llegar a lo que llamamos la “era postantibiótica” –dice–. Tendremos antibióticos disponibles en las farmacias, pero las bacterias evadirán su mecanismo de acción. Entonces, los pacientes van a fallecer.
El doctor Resurrección sabe de lo que habla.
No solo es infectólogo. Es el responsable del uso racional de antibióticos en el Dos de Mayo. Lleva años viendo cómo el uso indiscriminado de medicamentos están incrementando la resistencia de las bacterias a los antibióticos.
Y a estas alturas tiene una certeza.
–El Perú es uno de los países con mayor tasa de resistencia bacteriana en el mundo.
Medicamentos ineficaces
La frase de Resurrección parece haber sido confirmada por un estudio dirigido por el Grupo de Investigación de Epidemiología Genómica de la Universidad Técnica de Dinamarca y publicado el 1 de diciembre en la revista Nature.
La investigación recolectó 757 muestras de aguas residuales urbanas de 101 países para identificar la presencia y abundancia en ellas de genes de resistencia a los antibióticos.
Según el epidemiólogo Antonio Quispe, el estudio reveló que el Perú es uno de los países líderes en resistencia antibiótica en el mundo.
–Lo que hace este estudio es ver la abundancia de genes resistentes en los países –dice–. Y este mapa en particular pone a Perú entre uno de los países en el que circulan bacterias con la mayor abundancia de genes resistentes.
Tanto Quispe como Resurrección señalan que en el país hay medicamentos tradicionales que a estas alturas se han vuelto ineficaces.
–El sulfametoxazol con trimetropina era un medicamento muy popular para el tratamiento de las infecciones gastrointestinales por bacterias –dice Quispe–. Pero hoy es completamente inútil, ya los médicos no lo usamos porque no sirve.
–El ciprofloxaxino, que cuando alguien tenía infección urinaria lo pedía en la farmacia, ya ha perdido totalmente su eficacia –dice, por su parte, Resurrección–. La amoxicilina, que se usaba para la faringitis, también ha perdido su eficacia. La cefalosporina hoy es altamente resistente a enterobacterias y a bacterias como el estafilococo. Y la ampicilina, la megacilina, es bien difícil que puedan funcionar en alguien que ha usado por mucho tiempo antibióticos.
¿Qué ocurrió? ¿Como es que las bacterias se volvieron resistentes a estos fármacos?
–La principal causa [de la resistencia antimicrobiana] es la venta indiscriminada de antibióticos sin receta en las farmacias –dice el doctor Resurrección–. Y, segundo, en los centros de primer nivel de atención los médicos prescriben antibióticos indiscriminadamente, incluso para infecciones virales.
Antonio Quispe apunta más alto. Él cree que la principal razón es el uso irresponsable de antibióticos en la producción de alimentos, en particular en el cultivo de frutas y hortalizas y en la crianza de animales.
–Tenemos una regulación muy laxa. En otros países tú no puedes usar tantos antibióticos para producir alimentos. Ni puedes comprar medicamentos en las farmacias sin una prescripción médica, eso solo ocurre en el Perú. Todo pasa por una mayor regulación y por aplicar sanciones cuando no se cumple.
Mayor regulación
¿Se está haciendo algo para atender este problema? El biólogo molecular Ronnie Gavilán, secretario técnico de la Comisión Multisectorial para enfrentar la Resistencia a los Antimicrobianos, dice que sí y que se están logrando avances.
El primero es la existencia misma de la comisión, desde el año 2019, y la generación permanente de información sobre el avance de la resistencia a los antibióticos en el país.
Gavilán destaca que en el 2019 se logró prohibir el uso de la colistina en la crianza de animales. Se trata de un fármaco que se usa como último recurso en los hospitales, cuando todos los demás antibióticos no han surtido efecto. Su uso industrial amenazaba con volverlo inservible. ¿Qué habría pasado entonces?
Otro de los avances importantes ha sido la creación de los Programas de Optimización del Uso de Antimicrobianos (PROA) en los hospitales del país, cuya misión es evitar que los médicos prescriban antibióticos sin saber antes a qué bacterias se enfrentan y cuál es su nivel de resistencia a este tipo de medicamentos.
Gavilán es consciente de que hay tareas pendientes. Por ejemplo, hacer cumplir la ley que prohíbe la venta de medicinas sin receta. Y limitar el uso de otros antibióticos en la industria alimentaria. Dice que, por lo pronto, las instituciones que integran la comisión están generando evidencia para convencer a los empresarios de que hay que enfrentar este problema.
–En los años 2021 y 2022, por la pandemia, ha habido un aumento muy grande de resistencia antimicrobiana –dice–. –Sabemos que este es uno de los mayores problemas de salud pública, no solo en el Perú sino en todo el mundo.












